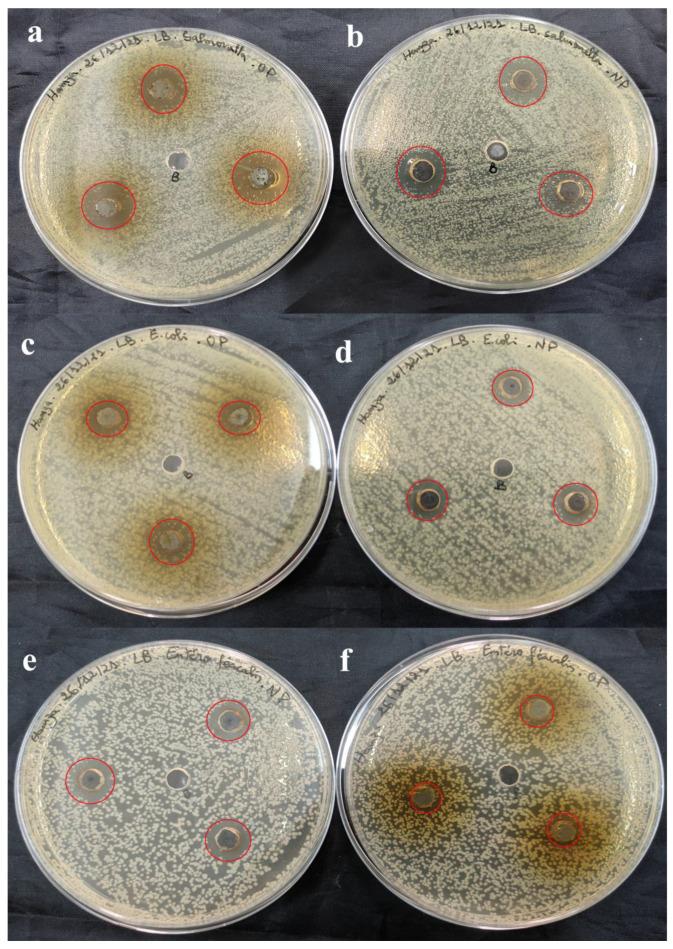
https://cdn.ncbi.nlm.nih.gov/pmc/blobs/832b/11673432/e35285b82e6f/bioengineering-11-01205-g010.jpg

从绿色化学到健康环境:银纳米颗粒作为双重抗氧化剂和抗菌剂推动生物医学与可持续废水处理
From Green Chemistry to Healthy Environments: Silver Nanoparticles as a Dual Antioxidant and Antibacterial Agents for Advancing Biomedicine and Sustainable Wastewater Treatment.
作者信息
Moussa Hamza, Hamid Sarah, Mameri Amal, Lekmine Sabrina, Tahraoui Hichem, Kebir Mohammed, Touzout Nabil, Dahmoune Farid, Ola Mohammad Shamsul, Zhang Jie, Amrane Abdeltif
机构信息
Laboratory of Management and Valorization of Natural Resources and Quality Assurance (LGVRNAQ), Faculty of Natural and Life Sciences and Earth Sciences, University of Bouira, Bouira 10000, Algeria.
Department of Biology, Faculty of Natural and Life Sciences and Earth Sciences, University of Bouira, Bouira 10000, Algeria.
出版信息
Bioengineering (Basel). 2024 Nov 28;11(12):1205. doi: 10.3390/bioengineering11121205.
The green synthesis of silver nanoparticles (AgNPs) using plant extracts is an eco-friendly method with potential for biomedical and environmental applications. This study aims to synthesize silver nanoparticles (SO-AgNPs) using L. extract and evaluate their antioxidant and antibacterial properties, positioning them as candidates for applications in sustainable biomedicine and wastewater treatment. L. extract was used to synthesize AgNPs under optimized conditions, with a 10% extract/AgNO₃ ratio and a reaction time of 180 min. The SO-AgNPs were characterized using ATR-FTIR, XRD, SEM, DLS, and Zeta potential analysis. The antioxidant activity of the extract and SO-AgNPs was evaluated using ABTS and DPPH radical scavenging assays. Antibacterial activity was tested against 11 bacterial strains and bacteria isolated from industrial effluent, with minimal inhibitory concentrations (MIC) determined for both the extract and SO-AgNPs. The SO-AgNPs demonstrated potent antioxidant activity, with IC₅₀ values of 0.233 mg/mL and 0.305 mg/mL in the ABTS assay, and 0.173 mg/mL and 0.185 mg/mL in the DPPH assay for the extract and SO-AgNPs, respectively. Antibacterial testing showed MIC values of 0.25 mg/mL for SO-AgNPs and between 3.12 and 6.25 mg/mL for L. extract against , , , , , and . For bacteria isolated from industrial effluent, the MIC values were 0.125 mg/mL for SO-AgNPs and 0.5 mg/mL for the extract. This study highlights the dual antioxidant and antibacterial capabilities of L. extract and SO-AgNPs, demonstrating their potential for use in both biomedical and environmental applications, including wastewater treatment.
利用植物提取物绿色合成银纳米颗粒(AgNPs)是一种具有生物医学和环境应用潜力的环保方法。本研究旨在利用[植物名称]提取物合成银纳米颗粒(SO-AgNPs),并评估其抗氧化和抗菌性能,使其成为可持续生物医学和废水处理应用的候选材料。在优化条件下,采用[植物名称]提取物合成AgNPs,提取物/硝酸银比例为10%,反应时间为180分钟。使用衰减全反射傅里叶变换红外光谱(ATR-FTIR)、X射线衍射(XRD)、扫描电子显微镜(SEM)、动态光散射(DLS)和zeta电位分析对SO-AgNPs进行表征。使用ABTS和DPPH自由基清除试验评估提取物和SO-AgNPs的抗氧化活性。针对11种细菌菌株和从工业废水中分离出的细菌测试抗菌活性,确定提取物和SO-AgNPs的最低抑菌浓度(MIC)。SO-AgNPs表现出强大的抗氧化活性,在ABTS试验中,提取物和SO-AgNPs的IC₅₀值分别为0.233毫克/毫升和0.305毫克/毫升,在DPPH试验中分别为0.173毫克/毫升和0.185毫克/毫升。抗菌测试表明,SO-AgNPs对[具体细菌名称]的MIC值为0.25毫克/毫升,[植物名称]提取物对[具体细菌名称]的MIC值在3.12至6.25毫克/毫升之间。对于从工业废水中分离出的细菌,SO-AgNPs的MIC值为0.125毫克/毫升,提取物的MIC值为0.5毫克/毫升。本研究突出了[植物名称]提取物和SO-AgNPs的双重抗氧化和抗菌能力,证明了它们在生物医学和环境应用(包括废水处理)中的潜在用途。